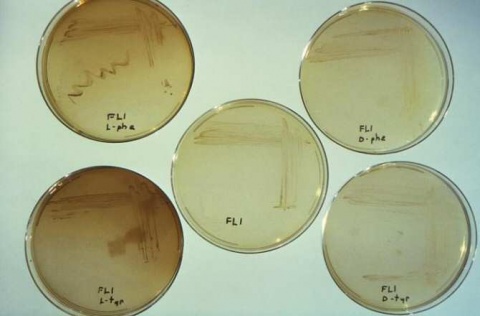

Matemáticas y ecología
Mejorar los métodos estadísticos para proteger las poblaciones de fauna salvaje
En las poblaciones humanas, es relativamente fácil calcular las tendencias demográficas y realizar proyecciones de futuro si se conocen datos de procesos básicos como los nacimientos y la inmigración (que aportan individuos) y las muertes y la emigración, que restan individuos. En el medio natural, por el contrario, comprender los procesos que determinan los patrones demográficos de la fauna salvaje es todo un reto de gran complejidad para la comunidad científica.
Aunque hoy en día se dispone de un amplio abanico de métodos para estimar los nacimientos y muertes en fauna salvaje, cuantificar la emigración y la inmigración ha sido históricamente difícil o imposible en muchas poblaciones de interés, particularmente en el caso de especies amenazadas.
Un nuevo estudio alerta de que obviar los datos sobre los movimientos de emigración e inmigración en fauna salvaje puede dar lugar a sesgos significativos en las proyecciones demográficas de las especies. Como consecuencia, las proyecciones sobre el futuro de las poblaciones de estudio a corto, medio y largo plazo pueden ser inadecuadas, lo que pondría en riesgo su supervivencia debido a la implementación de estrategias de conservación erróneas o poco eficaces.
Firman este estudio los expertos Joan Real, Jaume A. Badia-Boher y Antonio Hernández-Matías, del Equipo de Biología de la Conservación de la Facultad de Biología de la Universidad de Barcelona (UB) y del Instituto de Investigación de la Biodiversidad (IRBio).
Este nuevo estudio sobre biología de poblaciones se basa en los datos recopilados de 2008 a 2020 sobre la población del águila perdicera (Aquila fasciata), una especie amenazada que en Cataluña se puede encontrar en las cordilleras litorales y prelitorales, desde el Empordà hasta las Terres de l’Ebre. En el trabajo, el equipo hace hincapié en la precisión de la metodología de análisis de viabilidad de poblaciones (PVA) para mejorar la gestión y la conservación de especies de vida larga en el medio natural.
«Los análisis de viabilidad de poblaciones son un conjunto de métodos que permiten proyectar la demografía de una especie hacia el futuro, principalmente para cuantificar la probabilidad de extinción de una determinada especie o población de interés», comenta Joan Real, profesor del Departamento de Biología Evolutiva, Ecología y Ciencias Ambientales y jefe del equipo de Biología de la Conservación.
«Hasta la actualidad —continúa—, estas proyecciones se han llevado a cabo mayoritariamente solo con datos de nacimientos y muertes, de modo que los procesos migratorios eran obviados a causa de la dificultad de obtener estos datos. Dicho de otro modo, intentamos realizar proyecciones demográficas sin considerar dos procesos demográficos clave».
En el estudio de la fauna salvaje, los modelos poblacionales que no incorporan la inmigración o la emigración «tienen una considerable probabilidad de llevarnos a proyecciones sesgadas sobre la tendencia futura de la población. Sin embargo, considerar explícitamente los procesos migratorios nos permite tener en cuenta todos los procesos demográficos clave que determinan la tendencia futura de una población», detalla el experto Jaume A. Badia-Boher, primer autor del estudio. «Esto nos permite ser mucho más precisos a la hora de realizar predicciones demográficas, y por tanto también a la hora de planear estrategias futuras de conservación».
El desarrollo de nuevos métodos estadísticos más sofisticados durante la última década ha permitido estimar la emigración y la inmigración de forma mucho más accesible que antes. Por tanto, incluir estos procesos dentro de los análisis de viabilidad poblacional es relativamente sencillo ahora.
«Esta nueva perspectiva puede implicar un avance relevante en la fiabilidad de los análisis de viabilidad poblacional, que nos permitirá estimar la tendencia futura de las poblaciones con mayor precisión y proponer acciones de conservación de forma más eficiente», explica el profesor Antonio Hernández-Matías. «Este hecho es de gran importancia dado que en el actual contexto de cambio global las tasas de extinción de especies van en aumento, y cada vez son más las especies que requieren acciones de conservación urgentes y eficaces para revertir su declive».
![[Img #72516]](https://noticiasdelaciencia.com/upload/images/05_2024/8305_mejorar-los-metodos-estadisticos.jpg)
Los resultados de un estudio del Equipo de Biología de la Conservación de la UB y el IRBio alertan de que hay que mejorar la metodología actual para calcular los cambios poblacionales de la fauna salvaje en riesgo a fin de poder aumentar su supervivencia en el futuro. (Foto: Equipo de Biología de la Conservación - Universidad de Barcelona. CC BY)
Aplicar los avances metodológicos para conservar la biodiversidad
Introducir cambios en la estructura y modelización de los análisis de viabilidad poblacional puede conducir a múltiples beneficios en muchos ámbitos del estudio y la conservación de la biodiversidad. «Los avances en el campo metodológico son efectivos cuando se aplican. Por ese motivo, sería indicado potenciar la aplicación de la nueva metodología en poblaciones y especies de interés en el ámbito de la conservación. Es prioritario dar a conocer estas metodologías a la comunidad científica, a gestores y a administración, a fin de priorizar las acciones de conservación con los mejores métodos disponibles», indican los autores del estudio.
«En el futuro, hay que seguir desarrollando nuevas metodologías como se ha hecho en este estudio, ya que son clave para entender cómo funcionan las poblaciones salvajes, qué medidas hay que implementar para conservarlas, y cómo hacer que estas medidas sean lo más eficientes posible. En el caso de las especies amenazadas como el águila perdicera, conocer las tasas de emigración e inmigración es clave para conocer el estado de autosostenibilidad de una población, y así implementar medidas de conservación eficientes», concluye el equipo.
El estudio se titula "Assumptions about survival estimates and dispersal processes can have severe impacts on population viability assessments". Y se ha publicado en la revista académica Biological Conservation. (Fuente: UB)